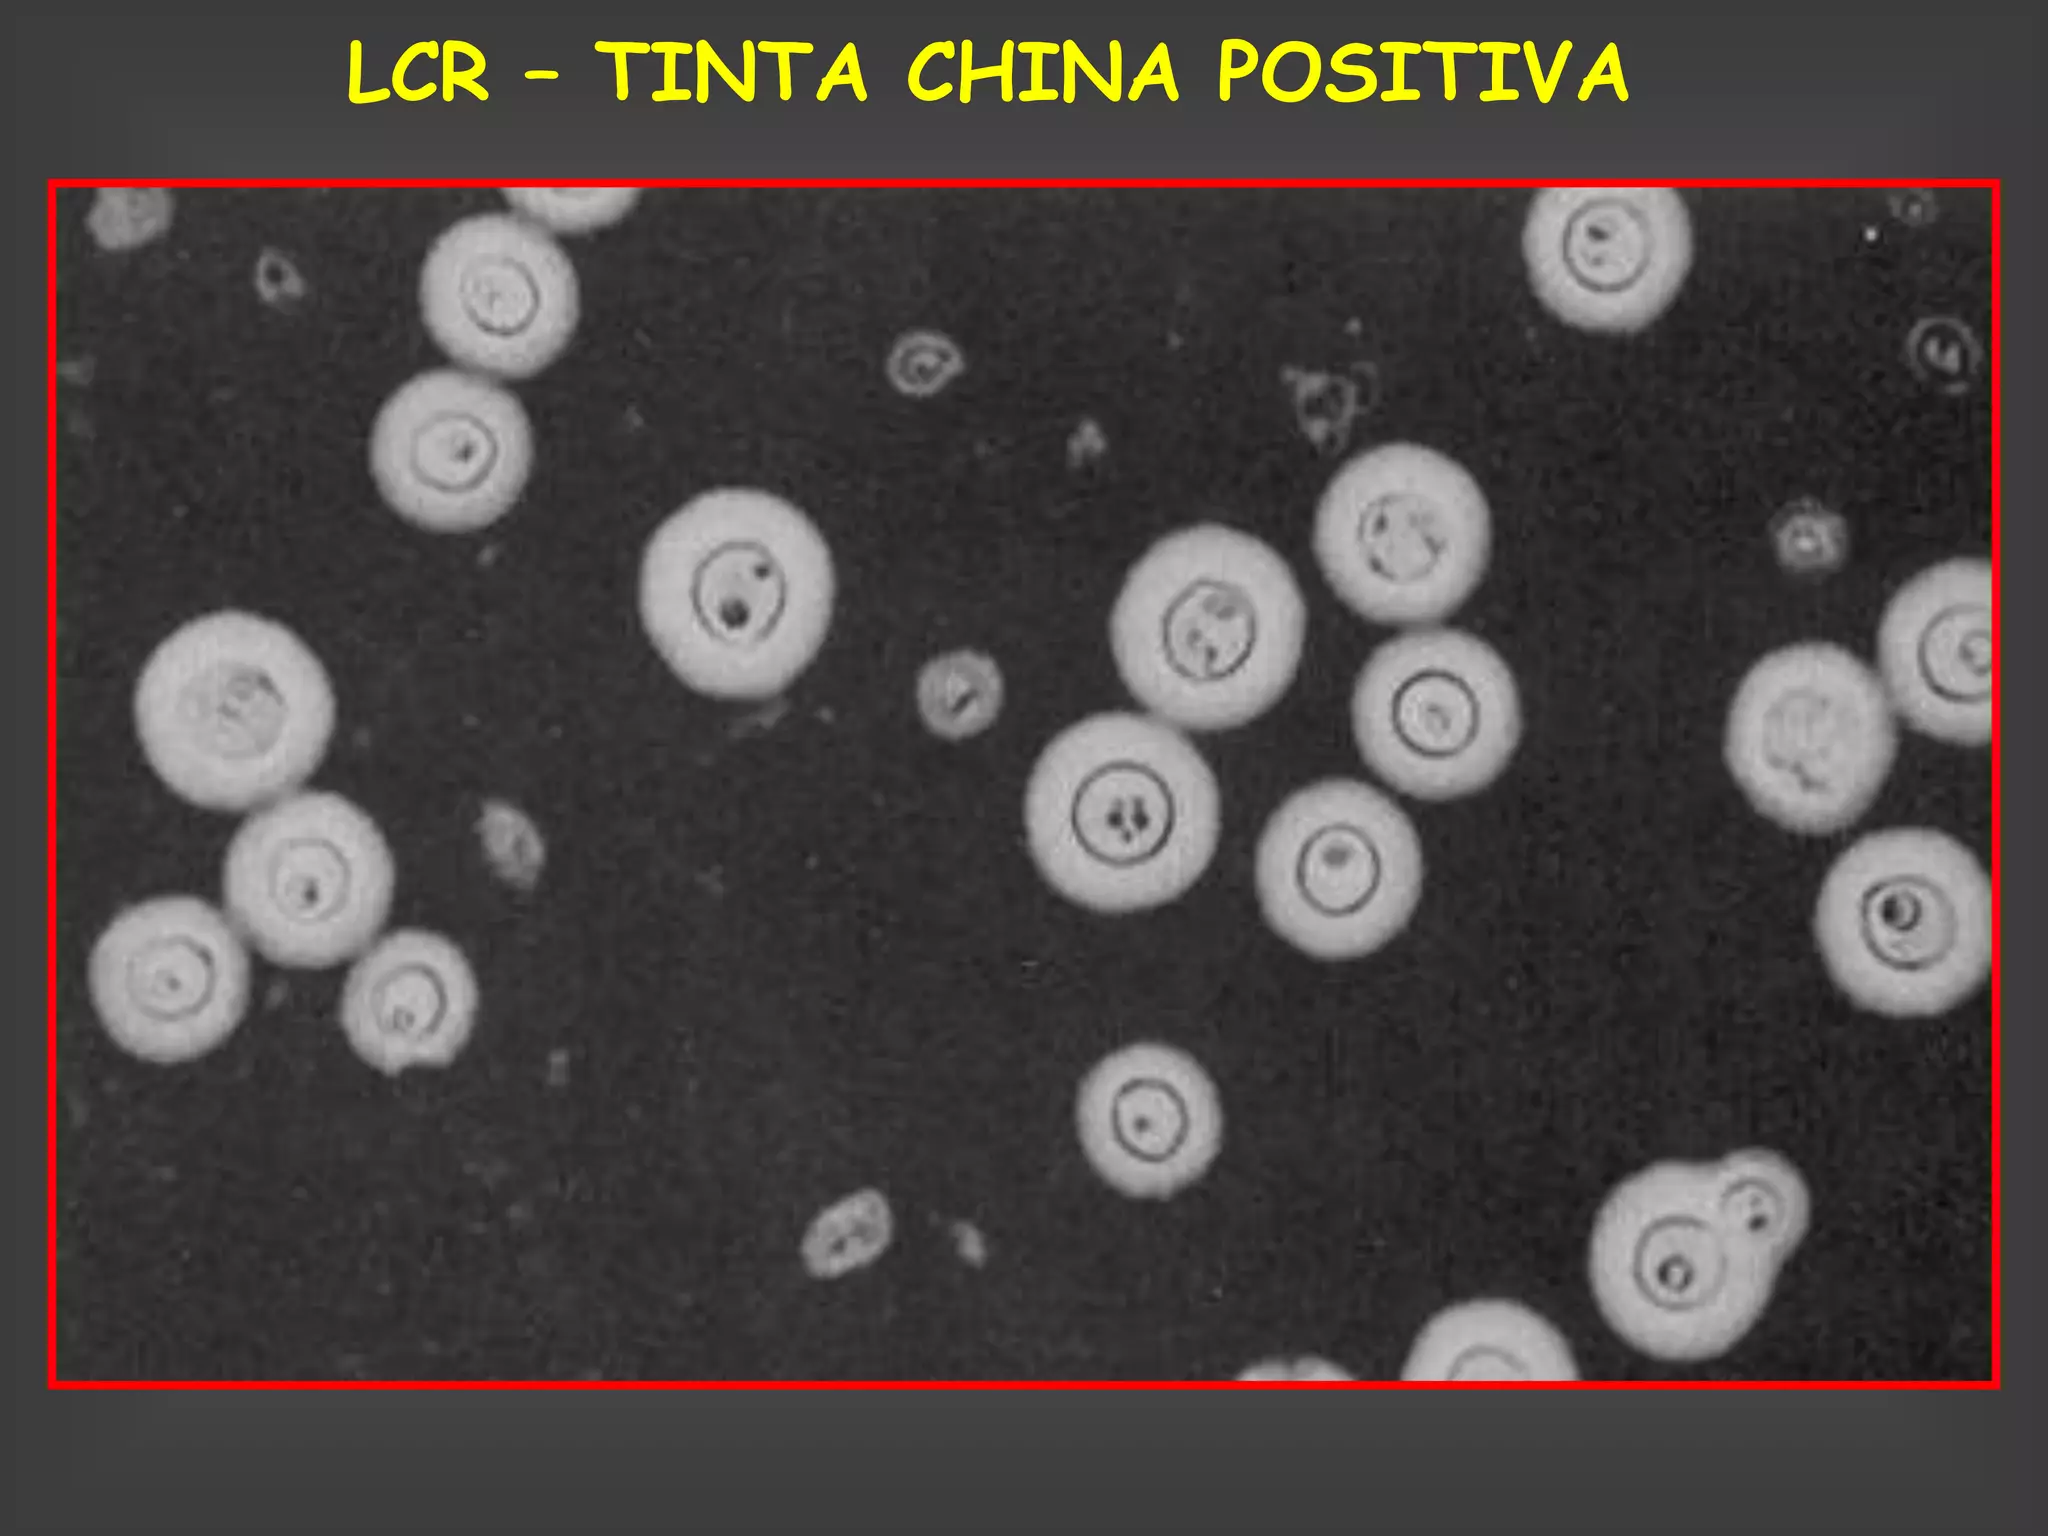
LCR – TINTA CHINA POSITIVA

El documento resume las principales enfermedades que comprometen el sistema nervioso central en pacientes con SIDA. Describe las infecciones oportunistas más frecuentes como criptococosis, toxoplasmosis, leucoencefalopatía multifocal progresiva y tuberculosis. También aborda las meningoencefalitis causadas por citomegalovirus, herpesvirus y neurosífilis, así como la enfermedad de Chagas. Explica los hallazgos clínicos, de laboratorio e imágenes de cada una y su tratamiento.